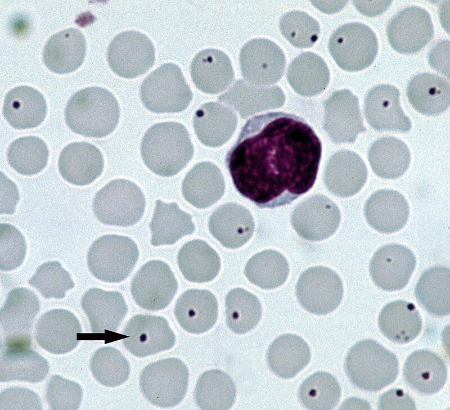
راه‌های انتقال آناپلاسموز در دام, پیشگیری از آناپلاسموز گوسفندان

محیط زیست
بیماری آناپلاسموز گوسفند چیست و چگونه درمان میشود؟ (راهنمای کامل دامداران)
منتشر شده
5 ماه پیشدر
توسط
بیتوته beytoote
بیماری آناپلاسموز گوسفند چیست و چگونه درمان میشود؟ (راهنمای کامل دامداران)
-
مجموعه: گیاهان،حیوانات و آکواریوم

بیماری آناپلاسموز گوسفند
آیا گوسفند شما دچار آناپلاسموز شده؟ نشانهها را بشناسید!

علائم آناپلاسموز در گوسفند
بیماری آناپلاسموز گوسفند
آناپلاسموز یکی از بیماریهای عفونی مهم در گوسفندان است که توسط باکتریهای جنس Anaplasma، بهویژه Anaplasma ovis، ایجاد میشود. این بیماری از طریق ناقلین مانند کنهها و حشرات گزنده منتقل شده و میتواند خسارات اقتصادی قابلتوجهی به صنعت دامداری وارد کند. در این مقاله، با استفاده از اطلاعات معتبر از منابع خارجی و ترجمه آنها، به بررسی جنبههای مختلف این بیماری، از جمله علل، علائم، تشخیص، درمان، پیشگیری و تأثیرات آن بر گوسفندان میپردازیم.
درمان آناپلاسموز گوسفند
آناپلاسموز چیست؟
آناپلاسموز یک بیماری عفونی منتقله از طریق کنه است که گوسفندان، بزها و برخی دیگر از نشخوارکنندگان را تحت تأثیر قرار میدهد. عامل اصلی این بیماری در گوسفندان، باکتری Anaplasma ovis است که به گلبولهای قرمز خون حمله کرده و باعث کمخونی و سایر عوارض میشود. این بیماری در مناطق گرمسیری و نیمهگرمسیری شایعتر است و در مناطقی با جمعیت بالای کنهها، مانند آفریقا، آسیا، جنوب اروپا و بخشهایی از خاورمیانه، بیشتر گزارش شده است. طبق منابع معتبر مانند Merck Veterinary Manual، آناپلاسموز میتواند از طریق کنههایی مانند Rhipicephalus و Dermacentor یا حشراتی مانند مگسهای خانواده Tabanidae منتقل شود.
عامل بیماری و نحوه انتقال
عامل بیماری:
Anaplasma ovis یک باکتری داخلسلولی اجباری است که در گلبولهای قرمز خون تکثیر میشود. این باکتری از طریق ناقلین بیولوژیکی (کنهها) یا مکانیکی (حشرات گزنده) منتقل میشود.
برخلاف Anaplasma marginale که عمدتاً گاوها را مبتلا میکند، A. ovis در گوسفندان بیماریزایی بیشتری دارد، اگرچه ممکن است عفونتهای بدون علامت نیز ایجاد کند.
نحوه انتقال:
کنهها: کنههایی مانند Rhipicephalus bursa و Dermacentor andersoni ناقلین اصلی هستند. این کنهها با تغذیه از خون دام آلوده، باکتری را به دامهای سالم منتقل میکنند.
حشرات گزنده: مگسهای خانواده Tabanidae (مگسهای اسبی) و پشهها میتوانند بهصورت مکانیکی باکتری را از دام آلوده به دام سالم منتقل کنند.
انتقال از طریق ابزار: استفاده از سوزنها یا تجهیزات جراحی آلوده در حین واکسیناسیون یا خونگیری نیز میتواند باعث انتقال بیماری شود.
انتقال عمودی: اگرچه نادر است، انتقال از مادر به جنین از طریق جفت گزارش شده است.
علائم بالینی
علائم آناپلاسموز در گوسفندان بسته به شدت عفونت، سن دام، وضعیت ایمنی و وجود عوامل استرسزا (مانند سوءتغذیه یا بیماریهای همزمان) متفاوت است. طبق اطلاعات منتشرشده در Veterinary Parasitology، این بیماری ممکن است بهصورت حاد، تحتحاد یا مزمن ظاهر شود.
علائم شایع:
کمخونی: به دلیل تخریب گلبولهای قرمز توسط A. ovis، دام دچار کمخونی شدید میشود که با رنگپریدگی مخاطات چشم، دهان و بینی مشخص است.
تب: افزایش دمای بدن (تا 41-42 درجه سانتیگراد) یکی از علائم اولیه است.
ضعف و بیحالی: گوسفندان مبتلا معمولاً بیاشتها شده و فعالیت کمتری نشان میدهند.
اختلالات گوارشی: اسهال یا یبوست ممکن است در مراحل پیشرفتهتر دیده شود.
زردی (ایکتر): تجمع بیلیروبین ناشی از تخریب گلبولهای قرمز میتواند باعث زردی پوست و مخاطات شود.
اختلالات تعادلی: در موارد شدید، عدم تعادل و مشکل در راه رفتن گزارش شده است.
کاهش وزن: به دلیل بیاشتهایی و استرس متابولیکی، دام بهتدریج وزن خود را از دست میدهد.

پیشگیری از آناپلاسموز گوسفندان
علائم در گوسفندان جوان و مسن:
گوسفندان جوان و برهها معمولاً علائم شدیدتری نشان میدهند، درحالیکه گوسفندان بالغ ممکن است عفونت را بهصورت بدون علامت یا خفیف تجربه کنند.
در گلههای تحت استرس (مانند حملونقل یا کمبود غذا)، بیماری میتواند بهصورت همهگیر ظاهر شود.
تشخیص
تشخیص آناپلاسموز نیازمند ترکیبی از بررسیهای بالینی، آزمایشگاهی و اپیدمیولوژیک است. طبق راهنمای Merck Veterinary Manual، روشهای تشخیص عبارتاند از:
بررسی بالینی:
مشاهده علائمی مانند کمخونی، زردی و تب در گوسفندان، بهویژه در مناطق اندمیک، میتواند مشکوک به آناپلاسموز باشد.
تاریخچه حضور کنهها یا حشرات گزنده در منطقه نیز سرنخ مهمی است.
آزمایشهای آزمایشگاهی:
رنگآمیزی گیمسا: نمونه خون لامگیری شده و زیر میکروسکوپ بررسی میشود. باکتریها بهصورت نقاط کوچک (مورولا) داخل گلبولهای قرمز دیده میشوند.
PCR (پیسیآر): این روش حساسترین ابزار برای تشخیص A. ovis است و میتواند حتی عفونتهای با بار باکتری کم را شناسایی کند.
آزمایش سرولوژیک: آزمایشهایی مانند ELISA برای تشخیص آنتیبادیهای علیه Anaplasma استفاده میشود، اما ممکن است عفونت فعال را از عفونت قبلی تفکیک نکند.
شمارش کامل خون (CBC): کاهش تعداد گلبولهای قرمز (RBC)، هموگلوبین و هماتوکریت همراه با افزایش MCV و RDW نشاندهنده کمخونی همولیتیک است.
تشخیص افتراقی:
آناپلاسموز باید از بیماریهای مشابه مانند بابزیوز، تیلریوز، لپتوسپیروز و مسمومیت با مس افتراق داده شود.

کنه ناقل آناپلاسموز
درمان
درمان آناپلاسموز در گوسفندان معمولاً با آنتیبیوتیکها انجام میشود، اما موفقیت درمان به تشخیص زودهنگام و شدت عفونت بستگی دارد.
داروهای اصلی:
تتراسایکلینها: اکسیتتراسایکلین (5-10 میلیگرم بر کیلوگرم وزن بدن، بهصورت عضلانی، هر 12-24 ساعت به مدت 3-5 روز) درمان استاندارد است. تتراسایکلینها باکتری را از بین برده و و علائم را بهسرعت کاهش میدهند.
ایمیدوکارب: این دارو در برخی کشورها برای درمان آناپلاسموز استفاده میشود، اما اثربخشی آن کمتر از تتراسایکلین است.
درمان حمایتی: در موارد کمخونی شدید، تزریق مایعات، مکملهای آهن و ویتامین B12 توصیه میشود. در شرایط بحرانی، انتقال خون ممکن است لازم باشد.
نکات مهم:
درمان باید تحت نظر دامپزشک انجام شود تا از مقاومت آنتیبیوتیکی جلوگیری شود.
گوسفندان بیمار باید از گله جدا شوند تا از انتقال بیماری توسط حشرات جلوگیری شود.
پیشگیری و کنترل
پیشگیری از آناپلاسموز نیازمند مدیریت جامع گله و کنترل ناقلین است. طبق توصیههای OIE Terrestrial Manual، استراتژیهای پیشگیری شامل موارد زیر است:
کنترل کنهها:
استفاده از کنهکشها (مانند فلومترین یا آمیتاز) بهصورت اسپری یا حمام ضدکنه.
مدیریت مراتع برای کاهش زیستگاه کنهها (مانند سوزاندن علفهای خشک یا کوتاه کردن پوشش گیاهی).
بازرسی منظم دامها برای شناسایی و حذف کنهها.
مدیریت گله:
قرنطینه گوسفندان جدید قبل از ورود به گله برای جلوگیری از معرفی دامهای آلوده.
اجتناب از استفاده مشترک از سوزنها یا ابزارهای جراحی بدون استریل.
بهبود تغذیه و کاهش استرس برای تقویت سیستم ایمنی دامها.
واکسیناسیون:
در حال حاضر، واکسن خاصی برای A. ovis در دسترس نیست، اما در برخی مناطق، واکسنهای تجربی علیه آناپلاسموز گاوی آزمایش شدهاند.
واکسیناسیون علیه بیماریهای مرتبط (مانند تیلریوز) میتواند خطر عفونتهای همزمان را کاهش دهد.
نظارت و آموزش:
آموزش دامداران برای شناسایی علائم اولیه بیماری و گزارش سریع به دامپزشک.
اجرای برنامههای نظارتی در مناطق اندمیک برای بررسی شیوع بیماری.
تأثیرات اقتصادی
آناپلاسموز میتواند خسارات اقتصادی قابلتوجهی به صنعت دامداری وارد کند.
تأثیرات این بیماری شامل موارد زیر است:
کاهش تولید: کمخونی و ضعف عمومی باعث کاهش وزن، تولید شیر و پشم در گوسفندان میشود.
تلفات: در گلههای بدون درمان، میزان مرگومیر میتواند به 30-50% در برهها و گوسفندان جوان برسد.
هزینههای درمانی: هزینههای مربوط به آنتیبیوتیکها، کنهکشها و خدمات دامپزشکی بار مالی سنگینی ایجاد میکند.
محدودیتهای تجاری: در مناطق اندمیک، محدودیتهای صادراتی دام زنده ممکن است اعمال شود.
تحقیقات اخیر و چشمانداز آینده
تحقیقات اخیر بر توسعه روشهای تشخیصی سریعتر و واکسنهای مؤثر متمرکز شده است. به گفته Frontiers in Veterinary Science، تکنیکهای جدید مانند PCR مبتنی بر نانوذرات و آزمایشهای سریع در محل (Point-of-Care) در حال توسعه هستند که میتوانند تشخیص را در مزارع تسهیل کنند. علاوه بر این، مطالعات ژنومیک بر روی A. ovis برای شناسایی اهداف جدید دارویی و واکسن ادامه دارد.
سوالات متداول درباره بیماری آناپلاسموز گوسفند
1. بیماری آناپلاسموز گوسفند چیست؟
بیماری آناپلاسموز گوسفند یک بیماری عفونی و غیرقابل انتقال مستقیم است که توسط کنهها منتقل میشود و گلبولهای قرمز خون را هدف قرار میدهد.
2. علائم اصلی بیماری آناپلاسموز در گوسفندان چیست؟
از جمله علائم این بیماری میتوان به تب، کاهش اشتها، لاغری، رنگپریدگی مخاطات، کمخونی شدید و کاهش وزن اشاره کرد.
3. آیا بیماری آناپلاسموز گوسفند قابل درمان است؟
بله، با تشخیص بهموقع میتوان از داروهای آنتیبیوتیکی مانند تتراسایکلین برای درمان این بیماری استفاده کرد و وضعیت حیوان را بهبود بخشید.
4 . چگونه میتوان از شیوع بیماری آناپلاسموز در گله جلوگیری کرد؟
کنترل جمعیت کنهها، ضدعفونی ابزار دامپزشکی، جلوگیری از استفاده مشترک سرنگ و تجهیزات، و حذف دامهای آلوده از گله از جمله راهکارهای مؤثر پیشگیری هستند.
5. آیا گوسفندان مبتلا به آناپلاسموز ناقل باقی میمانند؟
بله، گوسفندانی که بهبود مییابند ممکن است ناقل باقی بمانند و بیماری را به سایر دامها از طریق کنهها منتقل کنند، بنابراین نظارت دائمی لازم است.
نتیجهگیری
آناپلاسموز گوسفندان یک بیماری چالشبرانگیز است که نیازمند توجه ویژه دامداران و دامپزشکان است. با شناخت دقیق علائم، استفاده از روشهای تشخیصی پیشرفته، درمان بهموقع و اجرای استراتژیهای پیشگیری، میتوان تأثیرات این بیماری را به حداقل رساند. آموزش دامداران، کنترل ناقلین و سرمایهگذاری در تحقیقات برای توسعه واکسنهای مؤثر، کلید مدیریت بلندمدت این بیماری است. با توجه به اهمیت گوسفندان در اقتصاد کشاورزی بسیاری از کشورها، مدیریت آناپلاسموز نهتنها به سلامت دامها، بلکه به پایداری اقتصادی جوامع وابسته به دامداری کمک میکند.
گرد آوری:بخش علمی بیتوته
شاید دوست داشته باشید

سردار شکارچی: تداوم جنایات در لبنان برای ایران قابل تحمل نخواهد بود
واکنش سخنگوی وزارت امورخارجه به راهزنی ارتش آمریکا علیه کشتیرانی ایران

باید از ظرفیت شهرداری برای بازسازی منازل آسیبدیده استفاده کرد

پژمانفر: افزایش حقوق کارگران ابلاغ شد

آرزوی دیرینه صنعتگران تهران در آستانه تحقق؛ تعیین تکلیف ۳۸ لکه صنعتی

پاسخ صداوسیما به بیانیه شورای اطلاعرسانی دولت درباره اینترنت

عراقچی: نقض آتشبس در یک جبهه، نقض آتشبس در تمام جبهههاست

سقوط MQ-۱؛ اعتراف تلخ واشنگتن به زوال برتری هوایی در غرب آسیا

تحلیلی بر سهگانه دفاع، انسجام و مذاکره مقتدرانه در جنگ تحمیلی سوم

نیکزاد: برگزاری جلسات علنی مجلس منوط به اذن رهبری است
قیمت طلا، دلار و سکه امروز شنبه 9اسفند 1405/ کاهش همه قیمت ها + جدول کامل

«پاستا آلفردو» به آلبانی رفت

ابولا در ایران؛ از شایعه تا زنگ خطر!
مانیکور در خانه

گلاب نابی که نذر حرم امام رضا(ع) شد

نمایش وحدت و همبستگی مردم در خیابانهای فامنین

فشارخون بالا چه بلایی سر ما می آورد
آخرین قیمت دلار امروز شنبه 9خرداد/ ریزش قیمت + جدول

جایزه بهترین گل سال را طارمی برد



جدیدترین اخبار پربحث